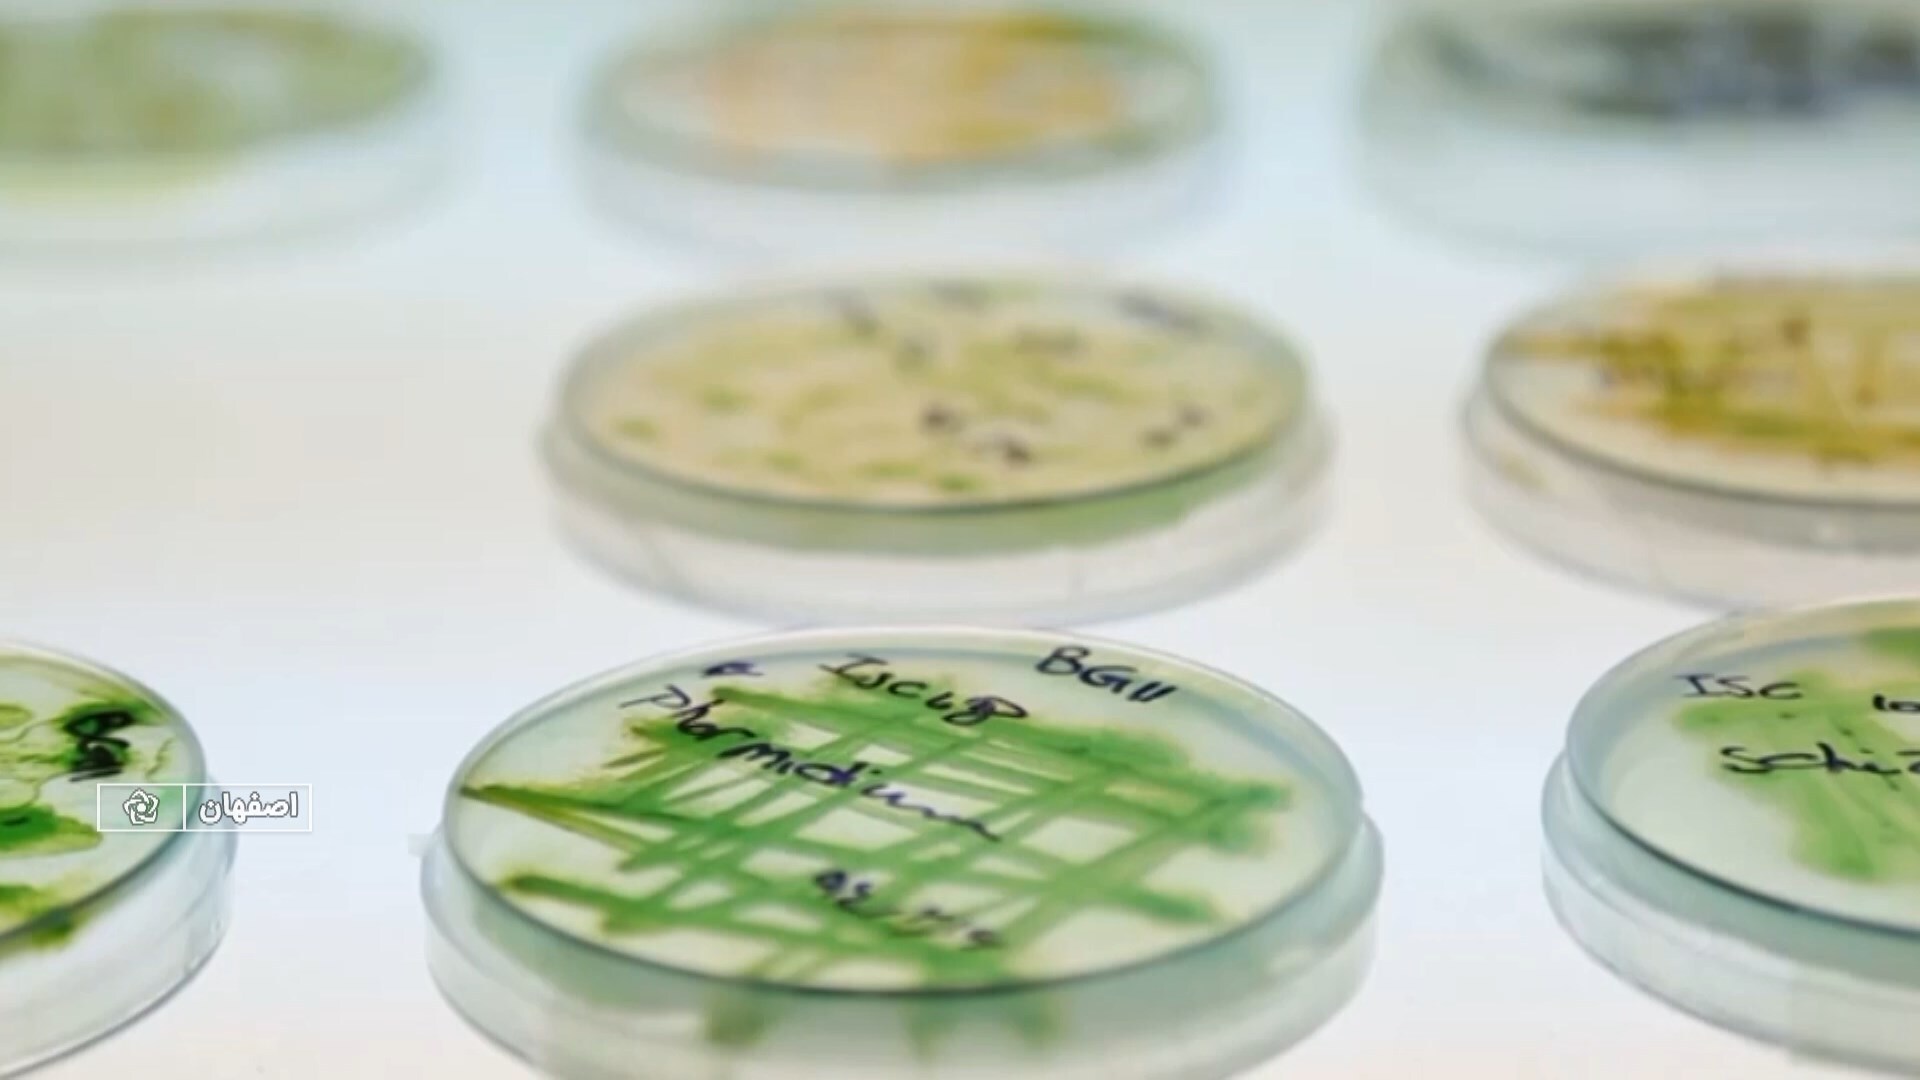

پخش زنده
امروز: -
دستاوردی در حوزه کشاورزی که با تلاش پژوهشگران مرکز تحقیقات و آموزش کشاورزی ومنابع طبیعی استان اصفهان محقق شده است.
به گزارش خبرگزاری صداوسیما، مرکز اصفهان؛ دانشیار مرکز تحقیقات و آموزش کشاورزی استان گفت: این مرکز در سال زراعی ۱۴۰۵-۱۴۰۴ موفق به خودکفایی در تامین بذر پایه گندم وجو شده است.
مهرداد محلوجی افزود: امسال با کاشت ۳۲ هکتار از اراضی سه مرکز تحقیقاتی گلپایگان، رودشت و کبوتر آباد بذور پرورشی مورد نیاز شرکتهای بذری تامین خواهد شد.
وی گفت: مبنای تولید و تکثیر بذر گندم و جووتامین بذر گواهی برای وسعت ۱۰۰ هزار هکتار برای کشت است.
دانشیار مرکز تحقیقات و آموزش کشاورزی استان افزود: مقدار مصرف بذر گندم و جو در شرایط بدون تنش ۲۰۰ کیلوگرم در هکتار ودر شرایط با تنش و غیربهینه ۳۰۰ کیلوگرم برآورد میشود.
مهرداد محلوجی افزود: سازگاری در اقلیم و تامین به موقع بذر وتولید محصول با کیفیت از ویژگیهای خودکفایی در تولید بذر گندم وجو در استان اصفهان است.
دانشیار مرکز تحقیقات و آموزش کشاورزی استان گفت: خودکفایی در تامین گندم وجو بعنوان دو محصول راهبردی در کشور است که میتواند امنیت غذایی را به همراه داشته باشد.